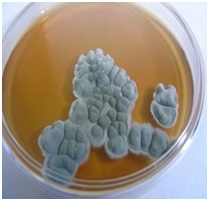
labio-3

Laboratório de Biocorrosão e Biodegradação (LABIO)
O Laboratório de Biocorrosão e Biodegradação (LABIO) desenvolve serviços especializados em parceria com empresas e outras instituições visando minimizar os impactos causados pelos processos de biocorrosão e biodegradação. Atua em soluções tecnológicas junto aos setores de Óleo & Gás, Mineração, setor Elétrico, Patrimônio Histórico e Cultural e no setor da saúde mais especificamente nas áreas de endodontia, ortodontia e implantodontia. O conhecimento adquirido com os trabalhos desenvolvidos desde 2004, ano de sua criação capacitou o laboratório de forma instrumental e humana para realizar os estudos.
Gerente:
• Walter Barreiro Cravo Junior, DSc em Engenharia Química - walter.cravo@int.gov.br
Substituto:
• Maurício Magalhães de Paiva, PhD em Biologia Celular e Molecular - mauricio.paiva@int.gov.br
Equipe:
• Márcia Tereza Soares Lutterbach, DSc em Biologia
• Ana Lúcia Chaves de Oliveira, Bióloga
• Bianca Naspolini, MSc em Engenharia Ambiental
• Danielle Aparecida, DSc em Engenharia Agrônoma
• Diogo Coutinho, MSc em Biologia
• Fabíola Araújo, Técnica em Secretariado
• Luiz André Pinto, DSc em Biomedicina
• Miriam Santana, Bióloga
• Viviane Oliveira, Bióloga
• Fernanda Cristina, Técnica em Química
• Renato Basso, MSc em Engenharia Química
• Matheus Ribeiro Marques, Técnico em Química
Estruturação do Laboratório:
• Setor de cultivo de microrganismos
O LABIO utiliza técnicas tradicionais de cultivo para quantificação, isolamento e identificação de bactérias aeróbicas e anaeróbicas, além de fungos leveduriformes e filamentosos. O laboratório possui um banco de cepas, onde estão armazenadas centenas de espécies microbianas que podem ser empregadas em diversos estudos e realização de bioensaios.
• Setor de biologia molecular
O setor de biologia molecular possui infraestrutura para realização de metodologias com foco nas moléculas de DNA e RNA, permitindo a aplicação de técnicas de extração, quantificação, clonagem e identificação de microrganismos. O trabalho realizado diretamente com a extração de ácidos nucleicos das amostras, possibilita o acesso aos microrganismos cultiváveis e não cultiváveis. Sendo assim, maior quantidade de dados sobre a diversidade da amostra são adquiridos, fornecendo as respostas com maior velocidade e precisão.

• Setor de bioensaios
Contamos com uma equipe qualificada para projetar e confeccionar sistemas em escala laboratorial, que permitem realizar ensaios estáticos e dinâmicos, simulando condições de campo, necessárias para o estudo da biocorrosão de materiais e biodegradação de produtos. O LABIO também é especializado na realização de ensaios de eficiência biocida, visando redução de custos e proteção ambiental.


• Setor de microscopia
Utilizando microscopia confocal e eletrônica de varredura ambiental, realizamos a correlação das suas imagens, aprofundando o estudo de biofilmes e da biocorrosão. O laboratório possui um citômetro de fluxo capaz de analisar grupos celulares com marcações distintas e estudos populacionais. Dispomos também dos microscópios e equipamentos do Centro de Caracterização em Nanotecnologia do Instituto (CENANO).



Linhas de Pesquisa
Na busca do atendimento das demandas do mercado e atento as tendências tecnológicas mundiais, o LABIO vem desenvolvendo juntamente com seus clientes algumas linhas de pesquisa:
- Avaliação da eficiência Biocida/Biocidas verdes
- Estudo de novas técnicas de controle da biocorrosão/ Métodos físicos
- Monitoramento da biocorrosão/Microbiologia clássica, Biologia molecular
- Estudo da aplicação de novos materiais/Ligas CRA
- Novas técnicas para tratamentos ortodônticos, endodônticos e implantodontia
- Biodegradação de patrimônio histórico e cultural.